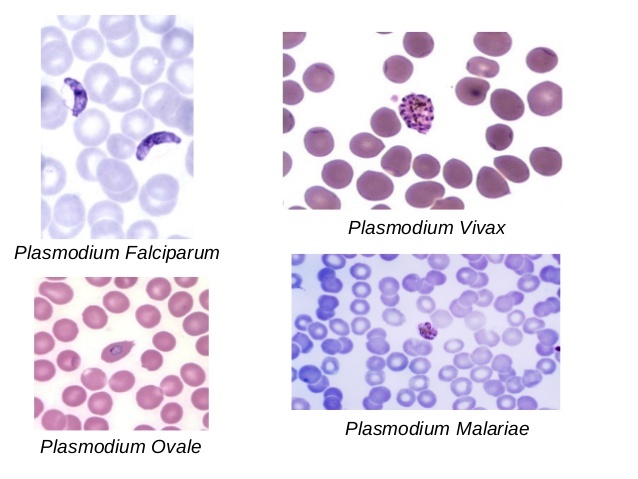

Paciente com quadro de febre elevada há 24h, sem foco aparente (urina normal, sem escarro, sem rigidez nuca…), com mialgia intensa, dor retro-orbitária, dor abdominal e sangramento de mucosas, e prurido cutâneo…
Diagnóstico, agente, incubação, melhor exame no momento, e conduta?
DENGUE com sinais de alarme
Vetor: Aedes aegypti // Agente: Flavivirus
Incubação: 3-15 dias // Subtipos: DEN 1, 2, 3, 4
Sinal de alarme: dor abdominal e sangramento mucosas
Teste isolamento viral (até 5 dia) ou antígeno NS1 (até 3 dia)
Conduta grupo C
Internar enfermaria, hidratar EV 20ml/kg/2h (até 3x)… melhorou 25/ml/kg/6h… Não melhorou: grupo D…
Paciente com quadro de febre elevada há 24h, sem foco aparente (urina normal, sem escarro, sem rigidez nuca…), com historia de ter frequentado mata fechada, com bradicardia, icterícia, hematêmese, e rápida piora do quadro clínico, evoluindo com uremia e aumento de enzimas hepáticas…
Diagnóstico, agente, tratamento e profilaxia…
Febre amarela grave
Vetor: Aedes aegypti (urbano), haemagogus (silvestre, BR) // Agente: Flavivirus // Incubação: 3-6 dias
Leve: Febre + sinal de faget/ecoturismo/mata fechada
Grave: lesão hepatorrenal (ictericia aumento de BD + hematemese + oliguria)
Teste: isolamento viral até 5 dia ou elisa IgM acima de 6 dias
Tratamento: notificar + suporte
Profilaxia: vacinação

Paciente com quadro de febre elevada há 10 dias, sem foco aparente (urina normal, sem escarro, sem rigidez nuca…), ictérico, com sufusão conjuntival, dor em panturrilhas, e diurese reduzida, evoluindo com piora do quadro e hemoptise…
Diagnóstico, agente, reservatorio, transmissão, exame P.O. e tratamento?
Leptospirose - Doença de Weil
Notificação compulsória
Agente: Leptospira interrogans // Reservatório: rim de ratos // Transmissão: enchente, esgoto, penetra pele submersa
Clínica: Vasculite infecciosa (Febre + sufusão conjuntival + dor em panturrilha)
Doença de WEIL: ictericia (aumento BD) + hemoptise (principal causa de morte) + oligúria (hipocalemia)
Diagnóstico: cultura // microaglutinação (P.O.)
Tratamento:
Grave: Penicilina G cristalina, ceftriaxone, diálise
Leve: Doxiciclina
Paciente com quadro de febre há meses, sem foco aparente (urina normal, sem escarro, sem rigidez nuca…), proveniente do nordeste, desnutrido, ictérico, com hepatoesplenomegalia, e pancitopenia …
Diagnóstico, agente, vetor, reservatorio, exames, e tratamento?
Calazar (Leishmaniose visceral)
Agente: Leishmania chagasi // Vetor: Lutzomyia longipalpis // Reservatório: cães, raposas // Incubação: 10 dias -24 meses
Maioria não adoece: baixa patogenicidade
Febre arrastada + esplenomegalia + pancitopenia + hipergamaglobulinemia policlonal
FEBRE POR UM TEMPÃO COM UM BAÇÃO
Exame parasitológico amastigotas (aspirado de M.O.) ou sorológico
Reação de montenegro geralmente -
Tratamento:
Anfoterecina B (desnutrido)
Definição de caso suspeito de dengue?
Febre (2 a 7 dias) + > 2 “problemas”
Quantas vezes um indivíduo pode pegar dengue no Brasil?
O que é a teoria de Halsted?
Até 4x (Subtipos: DEN 1, 2, 3, 4 )… subtipo 5 não existe aqui
Isso porque não confere imunidade para outro sorotipo
Inclusive, segundo a teoria de Halsted, uma infecção subsequente a outra pode ser pior pois a defesa contra o primeiro sorotipo pode causar tempestade citoquimica
Definição de dengue com sinais de alarme?
Suspeita de dengue + > 1 sinal de alarme + internação
Qual o período de maior vulnerabilidade de indivíduo com dengue?
48 horas subsequentes a melhora da febre (que acontece entre 3o e 4o dia)
Definição de dengue grave?
Síndrome do extravazamento plasmático
Suspeita de dengue + > 2 sinais de gravidade
Como realizar o diagnóstico de dengue e como avaliar o risco de sangramento?
Diagnóstico
Risco de sangramento: PROVA DO LAÇO

Como realizar o tratamento em casos de dengue?
Notificação compulsória semanal (se óbito, imediata)
Sintomáticos (exceto AAS e AINEs pela plaquetopenia)
Classificar e hidratar

Paciente com quadro de febre elevada agudamente, sem foco aparente (urina normal, sem escarro, sem rigidez nuca…), com rash e poliartralgia intensa, distal e simétrica…
Diagnóstico, agente, incubação, e conduta?
Chikungunya fase aguda
Vetor: Aedes aegypti, culex, anopheles // Agente: alphavivirus
Incubação: 3-15 dias
Febre dos que se torcem (poliartrite simetrica distal)
Conduta: repouso + analgesia (refratarios: opioides)
Quais as fases da Chikungunya e como tratar cada fase?
Chikungunya
Notificação compulsória
Paciente com quadro de febre baixa aguda, sem foco aparente (urina normal, sem escarro, sem rigidez nuca…), associada a rash pruriginoso nos primeiros dias e conjunntivite não purulenta…
Diagnóstico, agente, incubação, associações, trasmissão e tratamento?
ZIKA
Notificação compulsória (imediata se gestante, óbito)
Vetor: Aedes aegypti, aedes albopictus // Agente: Flavivirus
Incubação: 3-15 dias // Transmissão: picada, vertical, sexual…
Febre baixa + conjuntivite não purulenta, rash pruriginoso, fadiga, cefaleia, artralgia, sintomas TGI
Neurotropismo: Sd Guillain Barre, microcefalia congênita
Tratamento: sintomáticos (evitar AINEs)
Paciente com quadro de febre elevada em crises (cessa por 2 dias e volta no terceiro), sem foco aparente (urina normal, sem escarro, sem rigidez nuca…), com icterícia e anemia…
Diagnóstico, agente, vetor, exame e ciclo?
Malária
Agente: Plasmodium vivax, falciparum e malariae // Vetor: Anopheles darlingi
Diagnóstico: gota espessa ou TR
Ciclo: 2 estapas (hepática e eritrocitária)
Principal alvo: hemáceas (febre ocorre com ruptura das hemaceas… em crises)
Vivax: deixa hipnozoitas (quiescentes)

Caracterize cada agente da malária quanto: tipo de febre, hematoscopia, e tratamento…
Tratamento se grave
Tratamento (imediato) se grave: artesunato 6 dias + clindamicina 7 dias
Qual exame mais sensivel, qual mais seguro e qual avalia grau de atividade de calazar?
Exame parasitológico (formas amastigotas)
Aspirado de M.O. (S 70%) mais seguro
Punção esplênica (S 95%) mais sensivel, risco de sangramento
Sorologia: TR, imunofluorescência indireta, rK39
rK39: avalia grau de atividade
Reação de montenegro: negativo se imunossupressão
Como tratar calazar?
Escolha: glucantime (antimonial pentavalente)… alarga QT
Anfoterecina B lipossomal se:
Gestante, graves, insuficiências, imunossupressão, <1 ano, > 50 anos, intolerantes, CI glucantime (cardiopatas)
Paciente com quadro de febre elevada há 24h, sem foco aparente (urina normal, sem escarro, sem rigidez nuca…), com historia de frequentar esgotos, com mialgia intensa, evoluindo com depressão miocardica e aumento da permeabilidade capilar…
Diagnóstico, agente, incubação, melhor exame no momento, e conduta?
Hantavirose
(historia clinica e epidemiologia entre dengue e leptospirose)
Agente: hantavirus familia Bunyaviridae
Transmissão: direto ou aerossol por fezes, urina, saliva de rato silvestre
Sindrome cardiopulmonar por hantavirus (SCPH): infiltrado pulmonar com depressão miocardica
Tratamento: suporte (dobutamina - choque cardiogenico, noradrenalina)

Paciente com quadro de febre elevada há poucos dias, sem foco aparente (urina normal, sem escarro…), com exantema maculopapular, dor retro-orbitária, plaquetopenia e meningoencefalite, além de plegia flácida reflexa, historia de viagem para Africa, com infestação de mosquitos…
Diagnóstico, agente, incubação, melhor exame no momento, e conduta?
Febre do Nilo Ocidental
“dengue” + encefalite/meningite/lesão do 2 neurônio motor
Agente: flavivirus (África, Ásia ocidental, Oriente Médio, América do Sul - Argentina)… BR não
Reservatório: Aves // Vetor: Culex // Incubação: 3-15 dias
Exame: IgM soro ou LCR
Tratamento: suporte

Paciente com quadro de febre elevada de inicio súbito, sem foco aparente (urina normal, sem escarro, sem rigidez nuca…), com cefaleia e mialgia e historia de picada de carrapatos, e aparecimento de exantema maculopapular palmoplantar entre 2o e 5o dia de evolução…
Diagnóstico, agente, incubação, melhor exame no momento, e conduta?
Febre maculosa brasileira
Agente: Rickettsia rickettsii // Reservatório: carrapatos Amblyomma (SE, SUL, BA, DF)
Diagnóstico: cultura/sorologia
Diferencial com Doença de Lyme (Borrelia, carrapato … + eritema migratorio, artralgias, meningite…)
Tratamento: cloranfenicol / doxiciclina

Paciente com quadro de febre elevada de inicio súbito, sem foco aparente (urina normal, sem escarro, sem rigidez nuca…), com cefaleia e mialgia e historia de picada de carrapatos, além de aparecimento de eritema migratorio, associado a artralgias…
Diagnóstico, agente, melhor exame no momento, e conduta?
Doença de Lyme
Agente: Borrelia
Eritema migratório: Sinal do alvo
Manifestação cardiaca: Bloqueio atrioventricular e miocardite
Tratamento: doxiciclina
